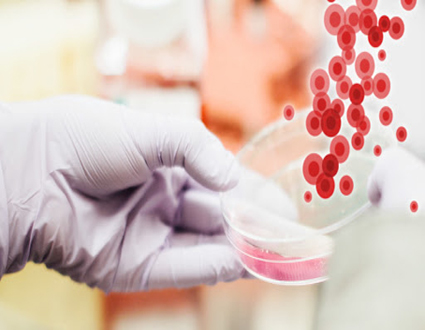

Кишинев республиканский неврологический центр
Неврология представляет собой междисциплинарную область медицины, специализирующуюся на изучении нервной системы (как в состоянии нормы, так и при наличии различного рода патологий).
Приватная клиника в Кишиневе предоставляет услуги лучших специалистов. Опытный невролог в частной клинике проконсультирует пациента и установит факторы развития заболевания.
Специалисты департамента Неврология в Кишиневе выделяют наиболее распространенные формы развития болезни:
- Заболевание наследственного характера.
- Болезнь, как последствие травматического повреждения нервной систремы.
- Неврологические заболевания, вызванные в результате осложнения после инфекционных болезней.
- Неврологические патологии, развивающиеся при неправильном образе жизни (например, постоянные стрессы, физическое и умственное переутомление, нарушение режима сна, неправильное питание и так далее).
Неврология в Кишиневе - Общая Информация
Врачи неврологи проводят качественную диагностику и подбирают методики лечения для следующих заболеваний:
- Искривление позвоночника.
- Неврозы.
- Невриты.
- Остеохондроз.
- Радикулит.
- Сосудисто-мозговая недостаточность.
- Атеросклероз.
- Грыжи межпозвоночных дисков.
- Вегето-сосудистая дистония, другое.
Платный прием у невролога в департаменте Неврология в Кишиневе.
Записаться на прием в частный центр необходимо в случаях, если присутствуют следующие симптомы:
- Нарушение речи.
- Неприятные ощущения, онемения и боли в области конечностей, шеи, грудной клетки, поясницы и живота.
- Головные боли, мигрени.
- Нарушение сна.
- Депрессия (симптом может дополнительно сопровождаться тревожностью).
- Нарушение координации движений.
- Обмороки.
- Шум в ушах.
- Резкое нарушение зрения.
Консультация, которую предоставляет хороший опытный невролог, позволяет осознать, что любое неврологическое заболевание чревато осложнениями.
Онлайн запись на прием, подробная консультация доктора невролога и своевременная диагностика позволяют подобрать оптимальный метод лечения болезни.Например, специалисты клиники AllClinic в Молдове проконсультируют, сколько стоит курс мануальной терапии, иглорефлексотерапии, психотерапии и медикаментозного лечения. Стоимость записи к неврологу высшей категории рассчитывается в индивидуальном порядке.
Цены на услуги лучших профильных специалистов приятно удивят. В клинике AllClinic в Молдове работают специалисты, прошедшие практику в лучших медицинских учреждениях Бухареста, Санкт-Петербурга, Израиля. Хороший врач невролог – залог успешной диагностики и лечения патологии. Ознакомиться со стоимостью услуг, записаться к специалисту и задать вопросы можно On-Line или позвонив по телефону 022 200 000.

Instituţia Medico-Sanitară Publică Centrul Republican de Diagnosticare Medicală din Moldova este o instituţie care îşi desfăşoară activitatea pe principiul autofinanţării, de non-profit, este creată şi activează în conformitate cu legislaţia în vigoare şi Statutul propriu.
Scopul principal al Instituţiei Medico-Sanitare Publice Centrul Republican de Diagnosticare Medicală este protecţia sănătăţii populaţiei, profilaxia, diagnosticarea, tratamentul şi reabilitarea bolnavilor, promovarea modului sănătos de viaţă.
Centrul a fost fondat în baza Hotărîrii Consiliului Miniştrilor al URSS nr. 628 din 19.05.1988 „Despre organizarea Centrelor de Diagnosticare Medicală”, ordinul Ministerului Sănătăţii al URSS nr. 400 din 15.06.1988 „Despre organizarea Centrelor de diagnosticare medicală”, a Dispoziţiei Consiliului de Miniştri al Republicii Moldova nr. 148-d din 05.08.1988 şi ordinul Ministerului Sănătăţii al Republicii Moldova nr. 281 din 01.09.1988 „Despre organizarea Centrului Republican de Diagnosticare Medicală”
Centrul este o formă nouă în acordarea de asistenţă medicală înaltcalificată populaţiei, focusată spre asigurarea accesului pacienţilor la metode contemporane de diagnosticare pentru toate instituţiile medico-sanitare din republică.
Centrul posedă o bază tehnico-materială contemporană, care permite de a implementa în practică cele mai avansate tehnologii de diagnosticare.
Director IMSP CRDM "Andrei Testemițanu"

"Succesul tratamentului maladiilor și preîntîmpinarea complicațiilor în mod primordial depinde de diagnosticarea corectă. Informația obiectivă despre starea sănătății organismului uman o putem afla numai în rezultatul efectuarii unei examinări complexe cu ajutorul utilajului modern și tehnologiilo .
Director IMSP CRDM "Andrei Testemițanu"

"Succesul tratamentului maladiilor și preîntîmpinarea complicațiilor în mod primordial depinde de diagnosticarea corectă. Informația obiectivă despre starea sănătății organismului uman o putem afla numai în rezultatul efectuarii unei examinări complexe cu ajutorul utilajului modern și tehnologiilor contemporane, dînd posibilitatea de a efectua un tratament corect, elaborînd programe concrete de reabilitare și profilaxie a maladiilor.
IMSP CRDM, fondată acum 25 de ani, este unică prin capacitățile sale și spectrul bogat de servicii care corespund standardelor naționale și internaționale.
Principiile de bază ale activității Centrului sunt accesibilitate, precizia, operativitatea, respectîndu-se totodată standardele de calitate în acordarea asistenței medicale populației."
Предлагаем жителям и гостям столицы все полезные телефоны медицинских учреждений.
Смотрите в справке Sputnik Молдова список номеров телефонов основных больниц, поликлиник, роддомов и других медучреждений Кишинева.
Экстренные службы
Единая экстренная служба — 112
Справочная о госпитализации больных — 022235285
Круглосуточная доставка медикаментов — 022840084
Больница скорой помощи — 022250817
Скорая стоматологическая помощь — 022726691 , 079455953

Единая служба о наличии лекарств в аптеках 022725510
Управление здравоохранения (ул.Букурешть.35) 022275209
Центр общественного здоровья мун. Кишинев (Санэпидемстанция) (ул.Хаждеу,49) 022574302
Национальная компания по медицинскому страхованию (бул. Г. Виеру,12) 022223166 , 022244747
Ассоциация фармацевтов (ул.Гренобля,149) 022727325
Агентство по медикаментам (ул.Короленко,21) 022737002
Национальный научно-практический центр скорой медицинской помощи (ул.Тома Чорба,1)
Поликлиника Министерства внутренних дел (ул.Г.Асаки,50) регистратура 022728000

Поликлиника железной дороги для взрослых (ул.Мунчешть,80) регистратура 022832484
Онкологический центр (ул.Тестимициану,30) отдел общей онкологии 022733384
Территориальное Медицинское Объединение (ул.31 Августа 1989,63) 022272427
Клиническая больница Министерства здравоохранения (ул. Пушкина,51)
Республиканская клиническая больница травматологии и ортопедии (бул. Штефан чел Маре,190)
Городская клиническая больница №1 (ул. Мелестиу,20)
Городская больница Архангела Михаила№2(ул. Архангела Михаила,38)
Больница Святой Троицы№3 (ул.А.Руссо,11)
Городская клиническая больница№4(ул.Колумна,150)
Муниципальная клиническая фтизиопневмологическая больница (ул.Гренобля,147) 022725185
Муниципальная дерматовенерологический диспансер (ул.Колумиа,55) 022273690
Муниципальный стоматологический центр (бул. Негруцци, 3) 022270376

Республиканская клиническая больница (ул. Тестемициану,29)
Больница железнодорожников (ул.Г.Кашу,37) приемный покой 022255706
Городской родильный дом при городской больницы №1(ул.Милестиу,20) бюро информации 022273750
Городской родильный дом №2 (бул. Ренаштерий,12) 022225560
Родильный дом при Центре матери и ребенка (ул. Буребиста,93) 022559664
Республиканская поликлиника при НИИ в области охраны здоровья матери и ребенка (ул.Буребиста,93) 022523121
Детская республиканская клин. больница им.Коцага(ул.В.Александри,2)
Детская клиническая больница№3 им.Игнатенко(ул.Гренобля,149) приемный покой 022208865
Детская инфекционная городская клиническая больница (ул.Ломоносова,79)
Детская городская клиническая больница №1 (ул. С.Лазо,7) 022245424
Муниципальный детский стоматологический центр (бул. Негруцци,3) 022270376

Рассказывает директор по медицинской части, врач высшей аттестационной категории Цуркану Евгений Павлович.
Евгений Павлович, в первую очередь, хотелось бы поговорить о том, когда был открыт Республиканский Медицинский Диагностический Центр, и что послужило толчком для его создания?
Республиканский Медицинский Диагностический Центр был основан 1 сентября 1989 года, еще при Советском Союзе. Правительством того времени было принято решение о создании в СССР 150-ти диагностических центров, оснащенных современной, высокоточной медицинской аппаратурой, по настоянию Министра Здравоохранения СССР Евгения Ивановича Чазова. Такая необходимость была связана с тем, что в лечебных учреждениях страны не было качественное медицинской аппаратуры. Надо было срочно что-то предпринять! Согласно этому решению Правительства, в Молдове таких центров должно было быть открыто два – один в Кишиневе, второй в Бельцах. В Кишиневе открытие было запланировано на 1989 год, а в Бельцах – в 1990 году. Но было одно НО! Подобные центры должны были быть открыты в новых зданиях, отвечающих современным требованиям, где бы такая дорогостоящая аппаратура была бы установлена в срок и использована максимально, не менее чем в 2-х сменах.
В 1988 году одна из союзных республик, которая по графику Постановления Правительства должна была получить аппаратуру и открыть Центр, не смогла предоставить необходимое помещение.
В то время, 1988 году, в Кишиневе сдавалось в эксплуатацию новое здание, в котором мы сейчас и находимся, предназначенное для пульмонологического центра. Министром Здравоохранения Молдовы в те годы был Кирилл Алексеевич Драганюк. Он быстро сообразил, что здание большое, современное, и в нем прекрасно уместятся два центра. Кстати, Кирилл Алексеевич был министром шестнадцать с половиной лет (так долго на этом посту пока не задерживался никто), он постоянно добивался всего самого нового и качественного для медицинских учреждений республики, будь-то аппаратура или другие медицинские услуги для улучшения качества обслуживания и лечения больных. Вот и к открытию этого центра он имеет непосредственное отношение. Можно сказать, что центр создан благодаря его блестящим организаторским способностям, вовремя и верно принять необходимое решение.
Вскоре в Кишинев приехала специальная комиссия, которая осмотрела новое здание и согласилась с тем, что оно соответствует всем требованиям. Сразу же было принято решение о том, чтобы необходимое оборудование было направлено в Молдавию. Центр получил его во второй половине 1988 года.
Работа кипела по всем направлениям! Рабочие завершали строительство Радиологического корпуса, набирались квалифицированные кадры.
С мая месяца 1989 года некоторые отделения и лаборатория начали принимать пациентов, а официальное открытие Центра состоялось в декабре месяце 1989 года, когда все было закончено и работало.
Какие же отделения и лаборатории функционировали тогда? Какие услуги предоставлялись?
Во всех документах четко обозначалось, что Диагностические Центры будут заниматься только исследованиями и анализами для уточнения диагноза, и в первую очередь, – выявлением онкологической патологии.
• отделение рентгенологии с компьютерной томографией;
• отделение абдоминальной ультразвуковой диагностики;
• отделение ультразвуковой диагностики сердца и магистральных сосудов;
• отделение функциональной диагностики;
• лаборатория ядерной медицины – дополнительно была открыта, но в спецификации Диагностических Центров не входила,
• отделение организационно-методической работы.
Где же взяли столько специалистов, способных работать на столь новом оборудовании?
Министерством Здравоохранения республики на должность заведующих отделений и лабораторий были приглашены опытные, со стажем и квалификационными аттестационными категориями специалисты, а большинство врачей ординаторов были отобраны из закончивших в том году Кишиневский Государственный Медицинский Институт, те которые хорошо показали себя в учебе, будучи студентами.
Для молодых врачей были организованы курсы специализации по необходимым специальностям на Факультете Усовершенствования врачей КГМИ, заведующие отделениями и лабораториями были направлены в Центральный Институт Усовершенствования Врачей в городе Москве, где были организованы подготовительные курсы специально для работающих в Диагностических Центрах. Врачи Центра усовершенствовали свои знания и в других городах: Ленинграде, Киеве, позже в Румынии, Чехии, Германии и др. странах.
Параллельно с формированием врачебного коллектива, формировался и коллектив медицинских сестер, который осваивал работу на новой медицинской аппаратуре и оборудовании.
Но со временем стали возникать и другие проблемы, которые необходимо было решать, дело ведь, было молодое.
О каких проблемах идет речь?
Дело в том, что пациенты проходили у нас назначенные им обследования и возвращались к специалистам по месту жительства, которые должны были установить диагноз и назначить соответствующее лечение. Но не все медики были знакомы с таким новым оборудованием, которым мы располагали, не все могли разобраться в результатах проведенных исследований. Стали возникать трудности в определении диагнозов и назначении лечения.
В то время отделение организационно-методической работы организовало и проводило конференции для врачей республики, как в г. Кишиневе, так и выездные, в города и районы республики, где врачи Центра выступали с разъяснениями тех заключений, которые они давали на основании обследования пациентов на имеющихся в Центре медицинских аппаратах и оборудовании.
По просьбе и настоянию пациентов, в 1991 году в Центре организовали консультативное отделение, где появились терапевт, эндокринолог, кардиолог, гастроэнтеролог, оториноларинголог, уролог, нефролог, аллерголог, невропатолог, гинеколог, гепатолог, офтальмолог. На сегодняшний день работает 21 врач-специалист, которые проводят консультации по 12-ти специальностям.
Отмечу еще, что все услуги в нашем центре тогда предоставлялись совершенно бесплатно, так как Центр является государственным, бюджетным медицинским учреждением. С самого начала в Центре была организована компьютеризированная регистратура, иначе был бы хаос, ведь желающих попасть в Центр было огромное количество.
А потом ситуация изменилась?
Все рано или поздно меняется, такова жизнь! Изменилась ситуация в стране, а, следовательно, произошли изменения и в наших стенах.
С 1990 года главным врачом нашего центра стал бывший министр здравоохранения Кирилл Алексеевич Драганюк. Это и помогло нам оставаться на плаву, так как это был отличный организатор и руководитель. Он всегда учил нас тому, что главное для врача – это больной человек, ему нужно уделить все свои знания и опыт в его лечении, все остальное отодвигается на второй план.
Пришло время, к сожалению, что с финансированием медицинских учреждений стало очень плохо, денег катастрофически не хватало. И именно Кирилл Алексеевич добился, чтобы с 1993 года Центр начал работать по контракту с Министерством Здравоохранения. Были определены цены на предоставляемые медицинские услуги, согласно затратам. Иначе выжить нам бы не удалось, ведь любая аппаратура нуждается в уходе, лаборатория в реактивах, и все это стоит немалых денег. По просьбе и настоянию пациентов, с разрешения Коллегии Министерства Здравоохранения, с 1994 года в Центре разрешили предоставлять платные медицинские услуги (10% от общего количества проведенных исследований и анализов). Сразу организовали кассы, чтобы деньги платились только официально.
С появлением Страховой Медицины, основную работу Центр выполняет согласно заключенному договору с Национальной Компанией Страховой Медицины. То есть, пациенты, нуждающиеся в определенных исследованиях и анализах, входящие в Единую Программу и имеющие обязательный полюс медицинского страхования, по направлению врача-специалиста (форма 027/е) с места жительства или республиканского медицинского учреждения, проходят данные исследования в Центре бесплатно. Желающим обследоваться самостоятельно или не имеющие полюс обязательного медицинского страхования – предоставляем платные медицинские услуги, согласно прейскуранту, утвержденному Правительством Республики Молдова.
Вы обслуживаете всю Молдову?
Конечно, пройти обследование в Диагностическом Центре может любой житель Молдовы согласно вышеуказанному порядку.
У Вас, наверное, постоянные очереди?
Ничего подобного! Работа организована грамотно, поэтому очередей практически не бывает, за некоторым исключением.
Например, очереди есть на сцинтиграфию костно-суставной системы. Но это связано с тем, что в Молдове только две гамма-камеры, а больных, которым требуется это исследование, очень много. Вот и приходится ждать неделями, а то и месяцами.
Да, и на компьютерную томографию и магнитно-резонансную томографию тоже случается, что приходится подождать несколько дней.
А в остальном, проблем нет.
Евгений Павлович, хотелось, чтоб Вы рассказали о тех отделениях, которые функционируют сегодня. И о тех специалистах, которые стоят во главе этих отделений.
С удовольствием! На сегодняшний день у нас функционирует 10 отделений:
• Отделение компьютерной томографии. Здесь на современном оборудовании ежедневно выполняются: компьютерная томография всех органов и систем, ангиографии и др. сложные исследования. В рентгенологическом кабинете выполняются все виды рентгенографий, урография, маммография. Результат исследования вы получите уже через 15 минут. Возглавляет это отделение доктор медицины — Сильвиу Кондря.
• Отделением Магнитно-Резонансной Томографии заведует первый специалист в этой области в Республике Молдова, врач высшей аттестационной категории – Виктория Корецки. В отделении выполняются на высоком уровне магнитно-резонансные томографические исследования.
• В отделении функциональной диагностики проводятся: мультифункциональный амбулаторный мониторинг (ЭКГ, АД) компьютерная электрокардиография, сонодопплерография, УЗИ сосудов (Дуплекс), компьютерная энцефалография, компьютерная реография и др. Во главе этого отделения трудится врач высшей аттестационной категории Анатолий Крецу.
• Отделение общей ультразвуковой диагностики, где на лучших аппаратах обследуют внутренние органы: печень, селезенку, почки, органы малого таза, щитовидную и молочные железы и др. И.о. заведующего отделением — Екатерина Пушкина, врач высшей аттестационной категории.
• Отделение ультразвуковой диагностики сердца и магистральных сосудов, где на современном оборудовании проводятся точные исследования сердца и сосудов. Отделением заведует врач высшей аттестационной категории Нина Дука.
• Отделение эндоскопии возглавляет врач высшей аттестационной категории Владимир Мологин. Врачи отделения проводят такие исследования как фиброгастродуоденоскопия, фиброколоноскопия с обязательными цитологическими и морфологическими исследованиями материала.
• Клинико-диагностическая лаборатория, иммунология и цитоморфология – ведущая лаборатория республики. Заведует лабораторией врач высшей аттестационной категории Любовь Рацук. Ежедневно здесь проводятся все существующие на сегодняшний день клинические, биохимические и иммунологические анализы, цитология и морфология эндоскопического и др. биологических материалов и много других видов анализов, используя только лучшие реактивы.
• Лаборатория ядерной медицины – где проводятся все виды сцинтиграфий (щитовидная железа, печень, почки, легкие, головной мозг, сердце, костно-суставная система). Заведует лабораторией врач высшей аттестационной категории Мария Шегова.
• Консультативное отделение. В нем трудится 21 врач по 12-ти специальностям. Заведует этим отделением врач кардиолог высшей аттестационной категории — Лилия Реница. Все консультации проводятся только платно, все необходимые исследования и анализы — также платно. Врачи-консультанты рекомендуют проводить назначенные ими анализы и исследования только в нашем Центре. Это повышает их ответственность за правильный диагноз и назначенное лечение. Согласно указаниям Министерства Здравоохранения, пациенты, имеющие полюс обязательного медицинского страхования и нуждающиеся в консультациях врачей-специалистов, по форме 027/е в данное отделение не направляются.
• Большой объем работы выполняет отделение мониторинга, оценки и интеграции медицинских услуг, которое проводит анализ, следит за качеством предоставляемых услуг, организует конференции и консилиумы для врачей. Возглавляет данное отделение Борис Горошенко, врач высшей квалификационной аттестационной категории.
Большое значение в Центре уделяется информационным технологиям. Внедрение медицинских информационных систем помогает значительно усовершенствовать рабочие процессы на самых разных уровнях, начиная от создания автоматизированного рабочего места врача до комплексной автоматизации учреждения.
Информационное преобразование учреждения было проведено в несколько этапов — построение сетевой инфраструктуры и подключение всех сотрудников к внутренней сети организации, автоматизация работы регистратуры, установка системы отображения информации для пациентов, внедрение медицинской карты пациента. Данная карта позволяет соединить в цифровом виде всю базу данных о пациенте, начиная с персональных данных и заканчивая всеми результатами проведенных анализов и исследований, архивации данных для последующих визитов пациента и гарантирования их точности и сохранности. Также ведется работа по созданию нового сайта Центра и подключение медицинской техники к информационной системе.
Не могу оставить без внимания и наш административный корпус: Генеральным директором Республиканского Медицинского Диагностического Центра является кандидат медицинских наук, доцент Андрей Николаевич Тестемицану.
Я, Евгений Цуркану, являюсь директором по медицинской части и работаю в центре с момента его основания.
Главная медицинская сестра Центра — Ирина Осояну.
Внушительный состав. Сколько же всего персонала в Диагностическом Центре?
Сегодня в Диагностическом Центре трудится 81 врач и 74 медицинских сестер. Разумеется, при наличии такой аппаратуры и оборудования в Центре работают и квалифицированные инженера.
Для обслуживания пациентов имеются в достаточном количестве санитарки, технические работники, водители.
Транспорт Диагностического Центра используется для транспортировки биологического материала из всех районов республики для проведения анализов в нашей лаборатории. И это во многом облегчает жизнь нашим пациентам — им нет необходимости приезжать с другого конца страны, чтоб сдать анализ, можно сделать это в своей поликлинике, а результат получить по факсу, телефону или электронной почте. Согласитесь, это очень удобно, экономит время, деньги и силы!
Сам собой напрашивается еще один вопрос: оборудование, которым центр располагает сегодня, столь же современное, каким было когда-то, ведь, время-то идет?
Конечно! Мы постоянно обновляем наше оборудование, чтобы всегда идти в ногу со временем. Без этого сегодня никак нельзя, наука не стоит на месте.
Смена медицинской аппаратуры и оборудования началась с 1995 года, когда благодаря работе по контракту с Министерством Здравоохранения, а позже и с НКСМ и платным услугам, появилась финансовая возможность закупить появившуюся более современную аппаратуру (компьютерный томограф, УЗИ-аппараты, лабораторные анализаторы и др.)
На сегодняшний день Центр располагает самыми современными ультразвуковыми аппаратами (единичные в Европе), компьютерным томографом (128 срезов), магнитно-резонансным томографом, оборудованием для анализов (метод Полимеразной Цепной Реакции) и многим другим.
Вся эта медицинская аппаратура и оборудование, в основном, было приобретено и установлено в Центре в 2012 году.
Скажите, пожалуйста, больные лечатся у Вас только амбулаторно, или существует и стационар?
У нас нет стационара. Мы проводим только обследования, диагностику, а также консультируем больных.
Но, в то же время, мы обследуем как амбулаторных, так и стационарных больных, которые приезжают, или их привозят к нам со всей республики.
Сколько пациентов в год Вы способны обследовать?
Ежегодно у нас проходят обследование более 350 тысяч пациентов со всей Молдовы, которым проводятся около 900 тысяч исследований, анализов и консультаций.
К Вам обращаются и взрослые, и дети?
В основном взрослые, а дети обследуются в Научно-Исследовательском Институте Охраны Здоровья Матери и Ребенка, который оснащен на современном уровне медицинской аппаратурой и оборудованием, и самое главное – квалифицированными специалистами. А я убежден, что каждый должен заниматься только тем, что он делает хорошо и качественно.
А какая научная работа ведется? С кем Вы делитесь накопленным опытом?
Наши врачи выполняют различные исследования, пишут статьи, различные научные работы и защищают диссертации.
На базе нашего Центра проходят обучение будущие специалисты по ультразвуковой диагностике, компьютерной томографии, магнитно-резонансной томографии, эндоскопии, лабораторному делу. Но все же основное направление нашей деятельности – это практическая работа, качественная и своевременная диагностика болезней.
Евгений Павлович, возможно, Вы поделитесь с нами Вашими планами на будущее? Что бы Вам хотелось преобразовать в центре в ближайшем будущем?
В первую очередь, хотелось бы, чтоб та аппаратура, что у нас есть, исправно работала. А еще, чтоб к нам обращались вовремя, на ранних стадиях болезни, а не в запущенной форме, когда уже сложно что-то сделать. Особенно это касается онкологических больных. Обидно, что люди не пользуются достижениями современной науки и техники, не обращаются к специалистам своевременно, теряют драгоценное время и, как следствие, часто – свою жизнь.
Хотелось бы приобрести еще одну гамма-камеру, как я уже говорил, их только две в Молдове, поэтому на это исследование существует очередность.
Кроме того, мы планируем в ближайшее время приобрести видеоколоноскопы и видеогастроскопы.
В настоящее время в Центре проводится реконструкция клинико-диагностичекой лаборатории, которая будет закончена к концу 2013 года. Она будет оснащена по последнему слову техники и будет лучшей не только в Молдове, но и в Европе и будет соответствовать Международному Стандарту ISO-FDIS 15189, к которым существуют специфические требования к качеству и компетентности.
Другими аппаратами мы снабжены на ближайшие лет пять, они у нас все новые, отвечающие последнему слову техники.
Хотелось бы обратится к медицинскому сообществу республики с просьбой не препятствовать направлению застрахованных пациентов на те исследования и анализы, которые включены в контракт НКСМ с РМДЦ.
РМДЦ принимает на исследования и анализы пациентов по форме 027/е только от профильных специалистов.
Приходите к нам, наши специалисты всегда помогут вам разобраться в самых сложных проблемах со здоровьем!
Спасибо за беседу!
Г.У.З. Республиканский Медицинский Диагностический Центр находится по адресу:

Международная ассоциация организаций в области неврологии и нейронаук (МАНН) является основанной на членстве некоммерческой общественной организацией, созданной по инициативе ведущих ученых-неврологов и неврологических научных центров стран СНГ.
Основная цель Ассоциации - содействие развитию клинической неврологии и фундаментальных нейронаук в странах, представители которых являются членами МАНН с проведением совместных научных исследований и реализацией многосторонних научных проектов, предполагающих использование объединенных возможностей сотрудничающих сторон.
Задачи и предмет деятельности:
- Развитие клинической неврологии и фундаментальных нейронаук в странах Ассоциации.
- Осуществление совместных научных исследований и реализация двух- и многосторонних проектов, предполагающих использование объединенных возможностей сотрудничающих сторон.
- Создание и курирование деятельности сотрудничающих неврологических центров в странах Ассоциации, организация сети головных (координирующих) учреждений по наиболее значимым проблемам неврологии из числа ведущих профильных научных центров (кафедр, клиник) стран Ассоциации.
- Согласованное планирование научных исследований, направленное на концентрацию ресурсов стран Ассоциации на наиболее актуальных и социально значимых проблемах неврологии и нейронаук.
- Организация научно-образовательных мероприятий в странах Ассоциации по проблемам клинической неврологии и фундаментальных нейронаук.
- Участие в формировании национальной политики в области неврологии в странах Ассоциации посредством взаимодействия с органами государственной власти, управления здравоохранением и наукой, государственными академиями, иными профильными правительственными и неправительственными организациями, средствами массовой информации.
- Осуществление согласованной политики в области получения национальных и международных грантов и других форм поддержки научных исследований.
- Взаимодействие с национальными и международными организациями по вопросам развития неврологической науки и образования в странах Ассоциации.
- Подготовка совместных рекомендаций по диагностике, лечению и профилактике заболеваний нервной системы.
- Участие в деятельности ученых и диссертационных советов, функционирующих на базе ведущих центров стран Ассоциации, в рамках существующих Положений и межгосударственных договоренностей.
- Организация научных конкурсов, учреждение именных медалей, дипломов и иных форм поддержки и поощрения научных исследований (в т.ч. молодых ученых) и образовательных программ.
- Пропаганда и распространение новейших достижений в различных областях нейронаук среди неврологических сообществ стран Ассоциации.
Членами Ассоциации могут быть юридические лица, непосредственно участвующие в осуществлении на национальном уровне научных исследований и образовательной деятельности в области клинической неврологии и фундаментальных нейронаук.
Решение о создании Ассоциации было принято в 2009 году, во время работы Пленума научного совета по неврологии РАМН. В апреле 2010 года Главным управлением Министерства юстиции Российской Федерации по Москве принято решение о государственной регистрации Международной ассоциации организаций в области неврологии и нейронаук и внесении записи в Единый государственный реестр юридических лиц.
В настоящее время в состав МАНН входят:
- Учреждение Российской академии медицинских наук Научный центр неврологии РАМН (Москва)
- Государственное учреждение "Институт геронтологии Академии медицинских наук Украины" (Киев)
- Общественная организация неврологов Республики Таджикистан "Нейрон" (Душанбе)
- Межрегиональная общественная организация "Общество по изучению головной боли" (Москва)
- Государственный Университет Медицины и Фармации им. Н. Тестемицану (Кишинев)
- Межрегиональная общественная организация "Общество по изучению боли" (Москва)
- Государственное учреждение "Республиканский научно-практический центр неврологии и нейрохирургии" Министерства здравоохранения республики Беларусь (Минск)
- Государственное учреждение "Институт неврологии, психиатрии и наркологии Академии медицинских наук Украины" (Харьков)
С 1998 года Академия медицинских наук Украины совместно с Российской Академией медицинских наук проводит ежегодные Международные конференции по актуальным вопросам неврологии. В работе конференций принимают участие более 1500 делегатов и гостей из всех регионов Украины, Российской Федерации, стран СНГ, Европы. Как и прежде, основные научные направления XIII Международной конференции "Актуальные направления в неврологии" посвящены наиболее актуальным проблемам современной неврологии. Значительное внимани уделяется новым диагностическим и лечебным технологиям, а также вопросам патогенеза, клиники и лечения нейроинфекций, заболеваний экстрапирамидной нервной системы.
В конференции принимают участие ведущие специалисты Украины, России, Белоруссии, Молдовы, Таджикистана и других стран.
Традиционным становится проведение в Крыму Общего собрания Международной Ассоциации организаций в области неврологии и нейронаук (МАНН) - Ассоциации, созданной по инициативе ведущих ученых-неврологов и неврологических научных центров стран СНГ для содействия развитию клинической неврологии и фундаментальных нейронаук и проведения совместных научных исследований, реализации многосторонних научных проектов. В программу конференции включены II Общее собрание Ассоциации, Школа МАНН, посвященная современному состоянию неврологической науки и Конференция молодых ученых МАНН.
Читайте также:


